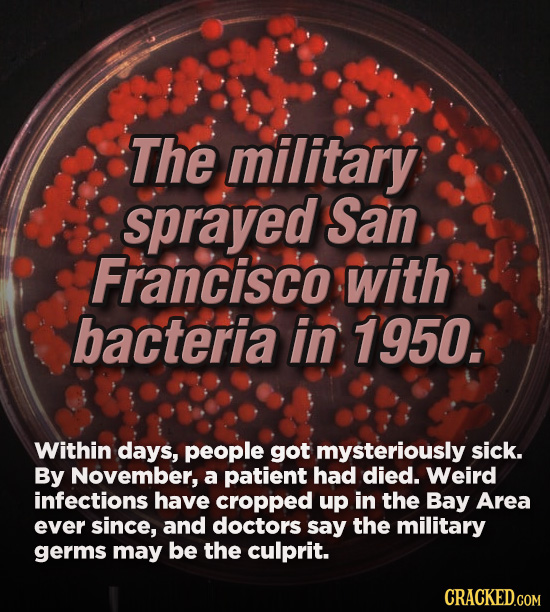
The military sprayed San Francisco with bacteria in 1950. Within days, people got mysteriously sick. By November, a patient had died. Weird infections

Conspiracies That Aren’t Theories, They Happened
Look, by and large, conspiracy theories are packed to the brim with certifiable nonsense. The vast majority of them are just fantasies, ploys, or rhetoric to cause division and derision. That said, you may want to keep filling your bunker with canned goods and you may not want to get rid of your tin foil hat just yet. While most conspiracy theories barely have enough evidence to earn an “theory” status over “horse crap," there are a few that actually aren't theories at all, but true history.
Was the Dalai Lama in the CIA's pocket? Did a businessman-based cabal try to overthrow Franklin Delano Roosevelt from the White House? Was the House Committee on Un-American Activities ironically founded by Soviets? The answer is “yes.”
Birds are indeed real and we did land on the moon, but these are the conspiracy exceptions to the rule. Take a look as some conspiracy theories that ended up being conspiracy facts.




Clubs

The Red Scare


The Dalai Lama



Scientology

Jack Anderson


The FBI

Franklin Delano Roosevelt



